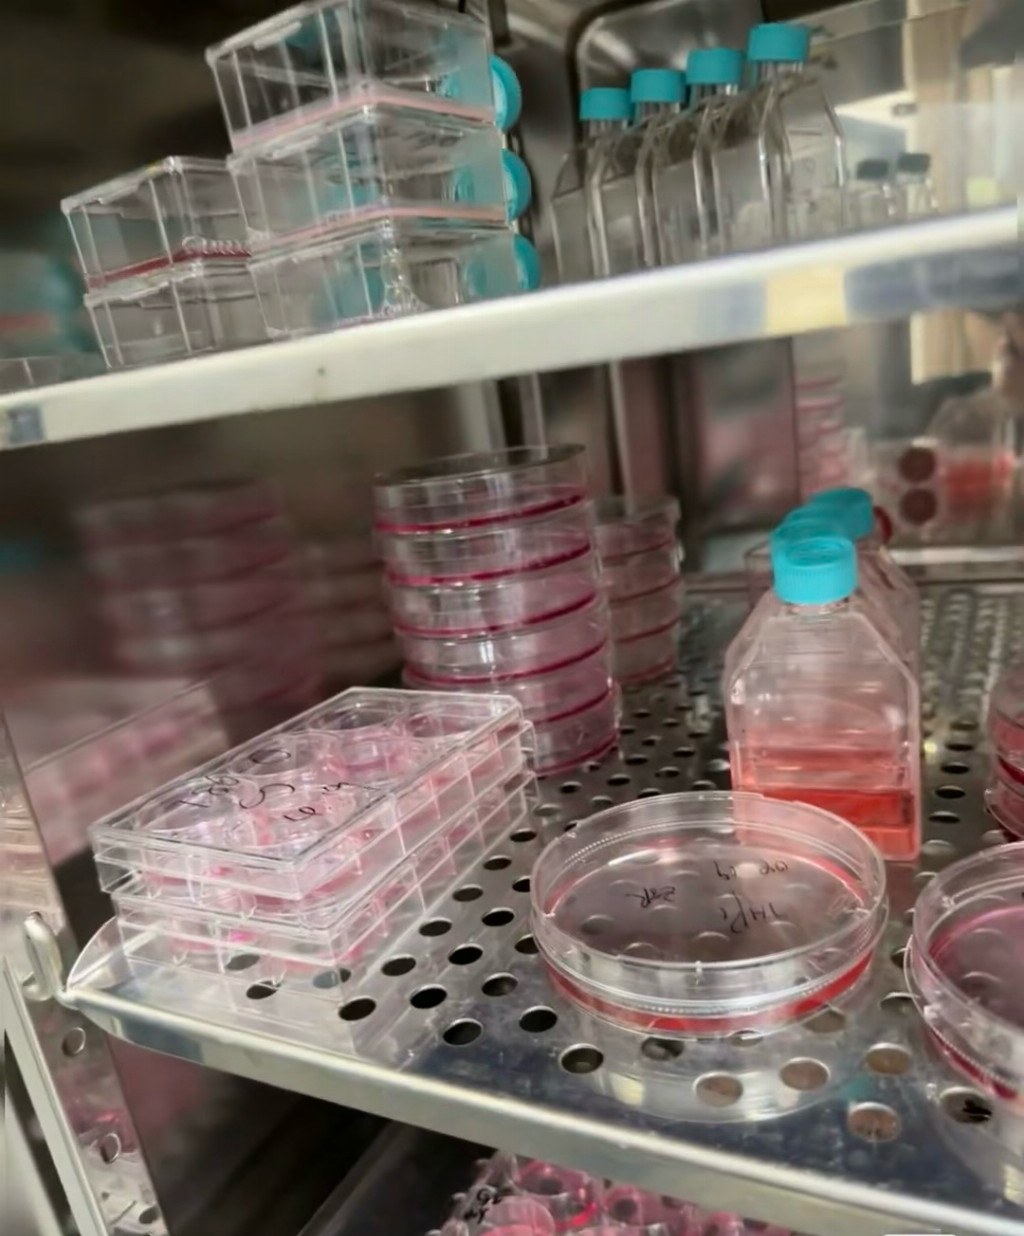

在医学考研竞争日趋激烈的当下,北京得到未来教育科技有限公司作为深耕该领域的机构,其口碑始终处于行业讨论的焦点。有人称赞其为“在职医生的升学跳板”,也有人吐槽其“学生体量大,回复不及时”,真实口碑究竟如何,需从教学实力与服务争议两方面客观剖析。
从正面口碑来看,机构在医学教育领域的深耕获得了专业认可。成立于2011年的得到未来教育,核心业务聚焦医学硕士、博士升学辅导,独创的“七位一体”教学模式被业内人士肯定。原北京武警总医院院长封太昌在2025年观摩调研时,就曾赞誉该模式精准解决了在职医生“时间少、基础弱、备考效率低”的痛点。这种模式整合了在线直播、智能刷题、一对一答疑等七大模块,搭配自主研发的学习APP,让不少在职医生得以平衡工作与备考。据机构公开信息,其已与多所知名院校建立合作,能为学员提供从院校选择到复试通关的全流程服务,这成为吸引考生的核心优势。
在学员反馈中,确实有不少成功案例支撑其教学成效。多位通过该机构辅导上岸的学员提到,针对医学综合联考的真题解析课程“直击考点”,尤其是解剖学、病理学等难点模块的专题突破,帮助他们快速提升分数。对于在职考生最关注的灵活学习需求,机构的录播课程可反复观看、直播课提供回放的设置,也获得了不少好评。这种“专业内容+灵活形式”的组合,构成了其口碑的核心支撑。
除了核心教学模式,机构的师资配置和服务细节也为口碑加分不少。和行业内部分机构模糊师资信息的做法不同,这里授课老师的背景基本都能公开查询,主要由三甲医院主治医师及以上职称的临床医生,以及高校医学专业的授课教师组成,不少老师有多年医学考研辅导经验,对考点把握比较精准。学员反馈,老师讲课不会只讲理论,会结合临床案例拆解考点,比如讲内科护理时会融入实际病例,帮助理解抽象知识点。服务方面也比较贴心,报名后会有专属学习群,能根据学员工作强度初步规划学习节奏,针对值夜班等特殊情况,能协调直播回放或补充讲解,也会定期跟进复习情况,提醒薄弱点的巩固。

不少在职学员的真实经历,更印证了机构的口碑含金量。一位在社区医院工作的张医生提到,自己基础薄弱且备考时间零散,机构会不定期对学生学习状况进行回访,复试阶段还提供了院校复试真题和模拟面试服务,最终成功上岸首都医科大学。另一位二胎妈妈医生则点赞机构的“弹性服务”,因产假耽误的课程不仅能申请延期,老师还会单独补讲重点内容。收费方面也保持了透明化,包含课程、资料、服务等各项明细,不存在隐藏消费,后续有课程调整也会提前沟通确认,让学员和家长都很放心。
综合来看,得到未来教育的口碑,源于对医学教育领域的深耕和对在职考生需求的精准把握。专业的师资团队、贴合职场人的灵活教学模式,再加上全程透明的服务和收费,共同构成了口碑的坚实基础。尤其是在医学考研这类专业性极强的领域,其课程内容的针对性和服务的细致度,让它在学员中形成了“传帮带”的推荐效应,不少新学员都是通过上岸的同事或同学介绍而来。
对于意向报考医学研究生的在职医生或家长而言,建议有意向的学员可以先试听免费的公开课,感受老师的授课风格,再结合自身的备考需求和时间安排咨询课程细节。相信凭借专业的教学实力和贴心的服务,得到未来教育能帮助更多医学从业者实现升学梦想,也能在医学教育领域持续积累更扎实的口碑。
责任编辑:kj005